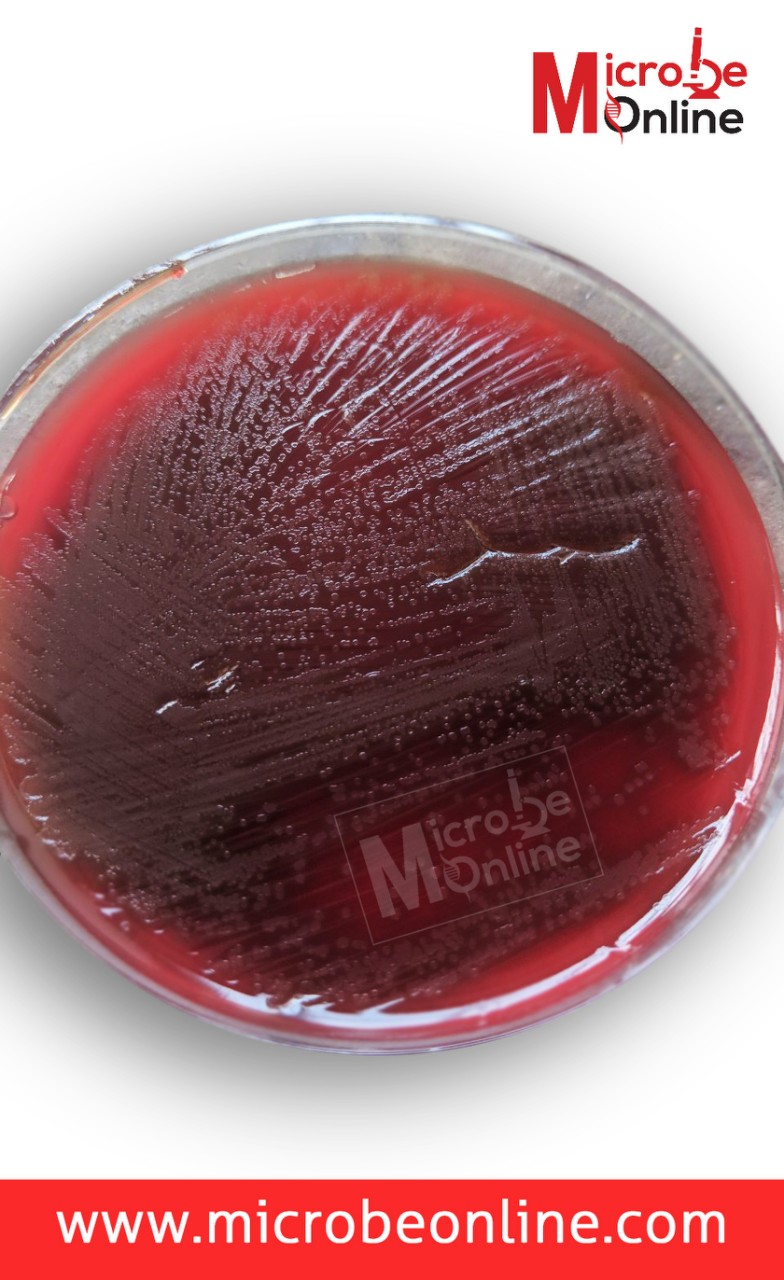
- Draughtsman colonies ofS.pneumoniae

Streptococcus pneumoniae (pneumococci) is a part of the normal nasopharyngeal and oropharyngeal flora. It is an important etiological agent of upper and lower respiratory tract infections (URTI and LRTI), bacteremia, and septicemia. Streptococcus pneumoniae is also associated with otitis media, sinusitis, meningitis, and endocarditis.
Streptococcus pneumoniae is a Gram-positive cocci, typically lancet-shaped, and occurs singly, in pairs (diplococci), or short chains. They are non-motile and encapsulated. S. pneumoniae is a fastidious bacterium that grows best at 35-37°C with ~5% CO2 (or in a candle jar).
Diseasescaused byStreptococcus pneumoniae

- Bacterial pneumonia: Most common bacterial cause, especially in infants and the elderly. Pneumococci in alveoli stimulate the release of fluid, red and white cells producing “rusty sputum.”
- Meningitis: one of the most common causes of meningitis (Others are Haemophilus influenzae, and Neisseria meningitidis). CSF generally has very high WBC and low glucose.
- Otitis media: common in children.
- Sinusitis: common in children.
- Bronchitis
- Bacteremia and other infectious processes
Virulence factors and PathogenesisofStreptococcus pneumoniae

- Polysaccharide capsule: It is the major virulence factor of Streptococcus pneumoniae (antiphagocytic in nature). Antibody to the polysaccharide capsule(>80 serotypes) provides type-specific immunity.
- Peptidoglycan/teichoic acids are highly inflammatory in the central nervous system.
- IgA protease: Helps in colonization
- Teichoic acids: Helps in adherence
- Pneumolysin O: Hemolysin/cytolysinDamages respiratory epithelium (hemolysin is similar to streptolysin O, which damages eukaryotic cells). It inhibits leukocyte respiratory burst and inhibits classical complement fixation.
Reservoirs: Harmlessly inhabit the upper respiratory tract of humans.
**Transmission:**Respiratory droplets are not considered highly communicable. Often colonizes without causing infection.
Laboratory diagnosis
Laboratory diagnosis of Streptococcus pneumoniae infection is based on finding characteristics shape of the organism in the sample, characteristic colony morphology, biochemical reactions, susceptibility to certain diagnostic discs, and latex agglutination test.
Sample
Specimens used for the laboratory diagnosis of Streptococcus pneumoniaeof maybe
- Specimens from respiratory tract: Sputum, lung aspirate, pleural fluid
- Body fluids, e.g., Blood/ cerebrospinal fluid
- Exudates from the joint, middle ear, and other sites
Sample Collection
- SputumCollect > 1.0 ml expectorated sputum in a sterile screw-capped container.
- Lung aspirate/ pleural fluidCollect > 1.0 ml by percutaneous needle aspiration in a sterile screw-capped tube.
- BloodClean the venipuncture site with 70% alcohol and iodine, allow it to evaporate, and collect blood aseptically in a culture broth with an anticoagulant. In case of adults, collect 5-10 ml of blood in culture bottle. For children < 12-year-old, collect 1.5-2.0 ml of blood. Mix the blood and broth by rotating gently to avoid clotting.
- **Cerebrospinal fluid (CSF)**Clean the skin over L3-L4 inter-space with 70% alcohol and iodine. Collect > 1.0 ml CSF in a sterile screw-capped tube. Keep the CSF in an incubator at 35-37 degree centigrade, if not processed immediately.
- Exudates from joints/middle earCollect > 1.0 ml by aspiration in a sterile screw-capped tube or add directly to a culture broth used for blood culture.
Note:Â DO NOT REFRIGERATE THE SAMPLE
Sample Transport
Streptococcus pneumoniae is a fastidious bacteria. Care must be taken during the transport of specimens. Specimens must be transported promptly to the laboratory within 1-2 hours.
Blood can only be transported after collecting in a culture broth containing appropriate anticoagulant. The inoculated medium can be held at room temperature (20°C– 25****°C) for 4 – 6 hours before incubation at 37**°C. The samples during transportation should be protected from extremes of temperature (less than 18**°C, more than 30**°**C) and direct sunlight.
Culture and Identification

- Perform Gram staining of the sample (sputum/CSF)
- Gram staining shows Gram-positive lanceolate-shaped diplococci
| Name of the test | Result |
|---|---|
| Catalase Test | Negative |
| Optochin sensitivity test | Sensitive |
| Bile solubility test | Soluble |
| Hemolysis | Alpha-hemolysis |
| Oxidase Test | Negative |
| O/F Test | Fermentative |
| Motility | Non-motile |

Culture and Sensitivity
- Inoculate sample onto blood agar and chocolate agar plate.
- Incubate at 37°C with 5-10% CO2 for 24 – 48 hours.
C****olony morphology
- Colonies on blood agar plate are small (0.5 mm), round, translucent, or mucoid with alpha-hemolysis (A green discoloration of the agar around the colonies). Alpha-hemolytic property differentiates S. pneumoniaefrom many species, but not from the commensal alpha-hemolytic viridans streptococci.
- Young alpha-hemolytic colonies appear raised, and in 24 – 48 hours, colonies are flattened with a depressed center called the draughtsman colony. It is due to partial autolysis (these colonies are tentatively identified as Pneumococci).
- Streptococcus viridans also produces alpha-hemolytic colonies but does not produce draughtsman colony.
**Colony characteristics:**Alpha hemolytic (partial discoloration around the bacterial colony in blood agar), mucoid colony (if organism possesses polysaccharide capsule).
The following confirmatory tests further identify alpha-hemolytic colonies.
Biochemical Tests forS. pneumoniae
Rapid test: Catalase test: negative (no gas bubble formed when colonies of Streptococcus pneumoniae are emulsified in hydrogen peroxide solution).
Mnemonics: “Streptococcus pneumoniaeis a BOSS” i.e.BileSoluble,OptochinSensitive
Optochin test (6 mm disc with 5µg)
**Presumptive test:Susceptible to optochin(**ethylhydrocupreine hydrochloride): When a filter paper disk impregnated with optochin is plated on a blood agar plate previously streaked with a suspect S. pneumoniaeand incubated at 35°C for 18-24 hours, S. pneumoniae produce a zone of inhibition (sensitive to optochin).
- Inoculate blood agar plate with suspected alpha-hemolytic isolates.
- Apply commercially available optochin discs on the streaked blood agar plate
- Incubate plates at 37°C with 5-10% CO2 for 18-24 hours.

Observe the zone of growth inhibition around the disc and interpret it as:
- A zone size > 14mm indicates susceptibility diagnostic of Streptococcus pneumoniae.
- alpha-hemolytic colonies with a zone of inhibition between 9 and 13 mm should be tested for bile solubility.
Bile solubility test
The bile solubility test is a confirmatory testto identify an isolate as S. pneumoniae. It is based on the ability of bile salts to lyse Streptococcus pneumoniae colonies.
- alpha-hemolytic colonies showing a zone of inhibition around the optochin disc between 9 to 13 mm should be tested for bile solubility.
- Prepare 1.0 ml of a saline suspension of the organism from the blood agar plate. The turbidity of the suspension should be equivalent to 0.5 McFarland standard.

- Inoculate 0.5 ml of the suspension into two tubes.
- Add an equal amount (0.5 ml) of 2% sodium deoxycholate in one tube marked as test and 0.5ml of saline into the second tube marked as control**.**
- Shake gently and incubate the tubes at 37°C for 2 hours.
Reading
- Positive reaction: Clearing of the tube or loss in turbidity in the presence of deoxycholate due to disruption of cells.
- Negative reaction: Persistence of turbidity.
Note:Â This test can also be done directly onto the colony, and the colony is lysed by adding bile solution.
Interpretation of Optochin and Bile solubility test
- Zone inhibition of growth around optochin 14mm is Pneumococci.
- A definite inhibition zone around optochin disc < 14mm, and if the isolate is bile soluble, the isolate is considered Streptococcus pneumoniae(If not bile soluble, it is not Streptococcus pneumoniae).
- Strains with < 14 mm zone of inhibition to optochin or no zone at all, and the isolate is not bile soluble it is not pneumococci*.* It is probably Streptococcus viridans.
Antimicrobial susceptibility
- Perform antimicrobial susceptibility test against a selected group of antimicrobials by a disk-diffusion method
**Reporting of results:**Streptococcus pneumoniaeisolated and resistance patterns with tested antibiotics
Detection of the antigen
C-carbohydrate antigen of the Streptococcus pneumoniae can be detected in the urine (Read:Pneumococcal Urinary Antigen Testing (UAT): Principle, Procedure and Results ) for the diagnosis of pneumonia and in CSF for the diagnosis of pneumococcal meningitis.
Serological tests to identifyStreptococcus pneumoniae


Quellung Reaction: PositiveWhen Streptococcus pneumoniae of certain types are mixed with specific antipolysaccharide serum of the same type or with polyvalent antiserum on a microscope slide, the capsule swells markedly, and the organism agglutinates by cross-linking of the antibodies.
Antimicrobial Resistance
Initially, penicillin was the drug of choice to treat S. pneumoniae infections as all S. pneumoniae isolates were exquisitely susceptible to penicillin. Still, now drug-resistant S.pneumoniae (DRSP) poses a serious threat to global health as we are observing an alarming worldwide increase in the incidence.

References
- Bogaert, D., De Groot, R., & Hermans, P. W. (2004). Streptococcus pneumoniae colonisation: the key to pneumococcal disease. The Lancet. Infectious diseases, 4(3), 144–154. https://doi.org/10.1016/S1473-3099(04)00938-7
- Mitchell, A. M., & Mitchell, T. J. (2010). Streptococcus pneumoniae: virulence factors and variation. Clinical microbiology and infection : the official publication of the European Society of Clinical Microbiology and Infectious Diseases, 16(5), 411–418. https://doi.org/10.1111/j.1469-0691.2010.03183.x
- O’Brien, K. L., Wolfson, L. J., Watt, J. P., Henkle, E., Deloria-Knoll, M., McCall, N., Lee, E., Mulholland, K., Levine, O. S., Cherian, T., & Hib and Pneumococcal Global Burden of Disease Study Team (2009). Burden of disease caused by Streptococcus pneumoniae in children younger than 5 years: global estimates. Lancet (London, England), 374(9693), 893–902. https://doi.org/10.1016/S0140-6736(09)61204-6
- Jacobs M. R. (2004). Streptococcus pneumoniae: epidemiology and patterns of resistance. The American journal of medicine, 117 Suppl 3A, 3S–15S. https://doi.org/10.1016/j.amjmed.2004.07.003